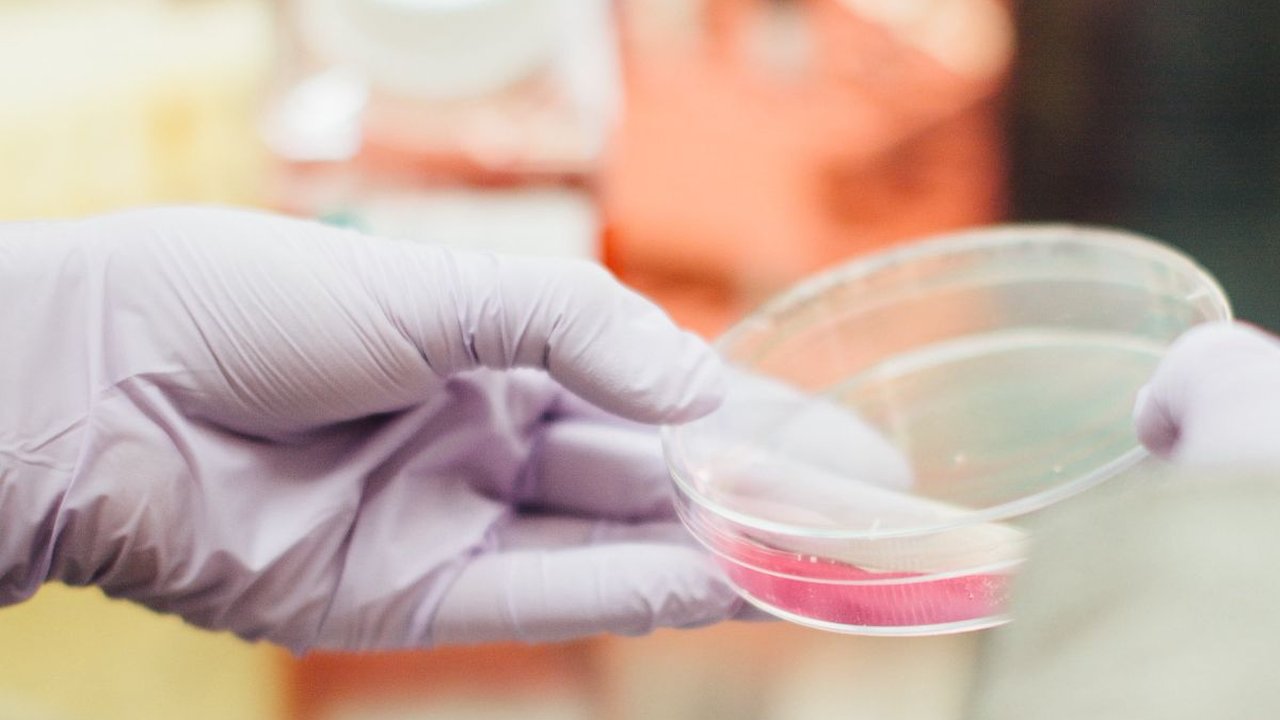
Mengenal Apa Itu Feromon, Zat Kimia Pemikat Lawan Jenis

Mengenal Apa Itu Feromon, Zat Kimia Pemikat Lawan Jenis
Apakah feromon dapat menjadi bagian aktif dari proses perilaku ketertarikan seksual?
Apakah feromon dapat menjadi bagian aktif dari proses perilaku ketertarikan seksual?

Mengenal Apa Itu Feromon, Zat Kimia Pemikat Lawan Jenis

Feromon adalah senyawa kimia yang diproduksi dan dilepaskan oleh organisme untuk memicu respons atau perilaku khusus pada organisme lain dari jenis yang sama. Secara umum, feromon berfungsi sebagai zat kimia pengirim sinyal untuk berkomunikasi antara individu dalam spesies yang sama.
Pada hewan, feromon digunakan untuk berbagai tujuan, seperti menarik pasangan, menandai wilayah, memicu respons agresif, atau menyinkronkan perilaku reproduksi. Contoh yang umum adalah feromon yang dilepaskan oleh betina untuk menarik jantan pada saat kawin. Pada manusia, meskipun peran feromon masih menjadi objek penelitian dan kontroversi, beberapa penelitian menunjukkan bahwa feromon mungkin memiliki pengaruh pada daya tarik seksual atau interaksi sosial.Menarik, bukan? Oleh karenanya, baca terus penjelasan lebih lanjut mengenai apa itu feromon di bawah ini untuk menambah pemahaman Anda.

Apa Itu Feromon?
Mengutip laman Web MD, feromon adalah bahan kimia yang digunakan hewan dan manusia untuk berkomunikasi. Tubuh mengeluarkan feromon melalui keringat, urine, air mani, ASI, dan cairan vagina.Teorinya, zat tersebut menimbulkan reaksi pada orang-orang di sekitar kita. Misalnya, feromon mungkin membantu kita menarik pasangan. Tak heran feromon terkadang disebut “bahan kimia cinta” karena efek ini.
Meski ada hubungan langsung antara feromon dan perkawinan di dunia hewan, dampak dan bahkan keberadaan bahan kimia ini pada manusia masih diperdebatkan.
Konsep asli feromon berasal dari penelitian terhadap serangga pada tahun 1930-an. Para peneliti menggunakan istilah “ektohormon” untuk menggambarkan hormon yang dikeluarkan serangga di luar tubuhnya.
Pada akhir tahun 1950-an, para ilmuwan telah mengganti nama zat yang dilepaskan oleh anggota spesies yang sama dengan feromon. Feromon tidak sama dengan hormon, meski namanya terdengar mirip. Hormon adalah pembawa pesan kimia seperti estrogen, kortisol, dan testosteron. Mereka bekerja di dalam tubuh untuk mengontrol hal-hal seperti pertumbuhan, suasana hati, dan fungsi seksual.
Sementara, feromon bekerja di luar tubuh. Mereka bertindak seperti sinyal bagi anggota spesies yang sama. Hewan melepaskan feromon untuk menandai wilayahnya, mencari mangsa, menarik pasangan, atau mengenali anggota lain dari spesies yang sama.
Bahan kimia ini tidak hanya memengaruhi ketertarikan seksual tetapi juga perilaku lain seperti:
- Suasana hati
- Ikatan orangtua-anak
- Koneksi sosial
- Pemikiran.

- Feromon pelepas langsung yang bekerja dan menimbulkan respons spesifik dari orang lain.
- Feromon pemberi sinyal yang memberikan informasi tentang orang yang melepaskannya. Misalnya, mereka membantu seorang ibu membedakan bayinya dengan bayi lain.
- Feromon modulator yang memengaruhi suasana hati dan emosi.
- Feromon primer yang memengaruhi hormon, misalnya selama kehamilan atau siklus menstruasi.

Feromon Pada Manusia
Hingga saat ini, masih belum jelas bagaimana proses feromon terjadi pada manusia. Manusia memang mempunyai organ VNO, tapi organ tersebut kecil dan mungkin kurang berkembang untuk memproses feromon seperti yang bisa dilakukan organ VNO pada hewan. Kemungkinan besar, manusia memproses sinyal-sinyal ini melalui sistem penciuman.Para ahli bahkan tidak sepakat apakah manusia menghasilkan feromon. Beberapa ilmuwan mengatakan manusia tidak memproduksinya. Sementara ilmuwan lain mengatakan feromon manusia memang ada, tetapi belum teridentifikasi.
1. Sinkronisasi menstruasi
Ada banyak teori tentang feromon dan siklus menstruasi wanita. Wanita yang tinggal bersama atau yang memiliki saudara perempuan mungkin memiliki siklus menstruasi yang selaras.
Ide mengenai sinkronisasi siklus menstruasi ini berasal dari penelitian tahun 1971 yang mengklaim feromon dapat mengubah siklus menstruasi wanita yang tinggal bersama-sama. Fenomena tersebut kemudian dikenal dengan nama efek McClintock, menyadur nama siswa yang melakukan penelitian tersebut.
Sejak saat itu, telah banyak penelitian lain yang membantah gagasan bahwa tinggal dekat atau bersama dengan wanita lain membuat siklus menstruasi mereka menjadi selaras. Para penulis penelitian baru ini mengatakan bahwa periode sinkronisasi yang ditemukan dalam penelitian tahun 1971 hanya terjadi secara kebetulan saja. 2. Kesuburan dan depresi
Meskipun masih banyak yang belum diketahui tentang feromon, penelitian sedang mencari cara untuk menggunakannya sebagai perawatan kesuburan bagi pasangan yang ingin hamil.
Misalnya, sebuah penelitian menemukan bahwa paparan feromon jantan memperlambat penuaan telur cacing gelang betina. Temuan seperti ini pada hewan mungkin membuka jalan bagi pengobatan infertilitas pada manusia.
Pasangan yang mengalami masalah seksual suatu hari nanti mungkin menggunakan feromon untuk meningkatkan hasrat mereka. Terlebih sudah ada bukti bahwa zat dalam keringat pria dapat meningkatkan mood dan fokus wanita.
Dan, wanita yang lebih fokus dan bahagia memiliki respons seksual yang lebih baik dan kepuasan yang lebih besar. Feromon juga mungkin dapat digunakan sebagai penambah suasana hati untuk meredakan depresi. 3. Pikat lawan jenis
Jika Anda sedang mencari pasangan idaman, feromon dalam aroma tubuh Anda dapat berperan dalam menarik pasangan. Feromon membuat Anda lebih menarik di mata calon pasangan dan sebaliknya.
Bagaimana orang lain memandang bau badan kita sebagai sesuatu yang menyenangkan dan seksi adalah proses yang sangat selektif. Biasanya kita mencium bau paling enak jika kita mencium seseorang yang memiliki kekebalan terhadap penyakit yang secara genetis sangat berbeda dengan kita.
4. Parfum feromon
Oleh sebab teori feromon dapat memikat lawan jenis, tidak mengherankan jika beberapa perusahaan kini memanfaatkan peran aroma dalam daya tarik pemasarannya.
Mereka menggunakan feromon untuk menjual produk yang dirancang untuk membantu orang-oramg menemukan cinta. Parfum dengan kandungan feromon mengklaim dapat “meningkatkan daya tarik” dan menarik perhatian objek yang Anda sukai.
Idenya mungkin terdengar menarik, namun belum ada bukti bahwa produk parfum feromon benar-benar berhasil. Malahan, ketika parfum ini diuji dalam penelitian, tidak hanya tidak meningkatkan daya tariknya, tetapi juga memiliki efek sebaliknya.
Kalung feromon, semprotan, dan produk lain untuk menenangkan hewan peliharaan yang cemas atau takut justru memiliki lebih banyak bukti yang positif.
























:strip_icc():format(webp)/kly-media-production/medias/8263328/original/010998600_1781883632-40d61759-e5b4-4164-b814-01ba8afee642.jpeg)
:strip_icc():format(webp)/kly-media-production/medias/8263345/original/081855100_1781887842-IMG_20260619_205520.v1.jpg)
:strip_icc():format(webp)/kly-media-production/medias/8263286/original/078037600_1781877229-IMG_4038.jpeg)
:strip_icc():format(webp)/kly-media-production/medias/8263316/original/003749800_1781881522-IMG_4134.jpeg)
:strip_icc():format(webp)/kly-media-production/medias/3544705/original/095321700_1629348830-ilustrasi-mayat_20170616_132436.jpg)
:strip_icc():format(webp)/kly-media-production/medias/8263288/original/023085200_1781878706-WhatsApp_Image_2026-06-19_at_20.31.33.jpeg)


















